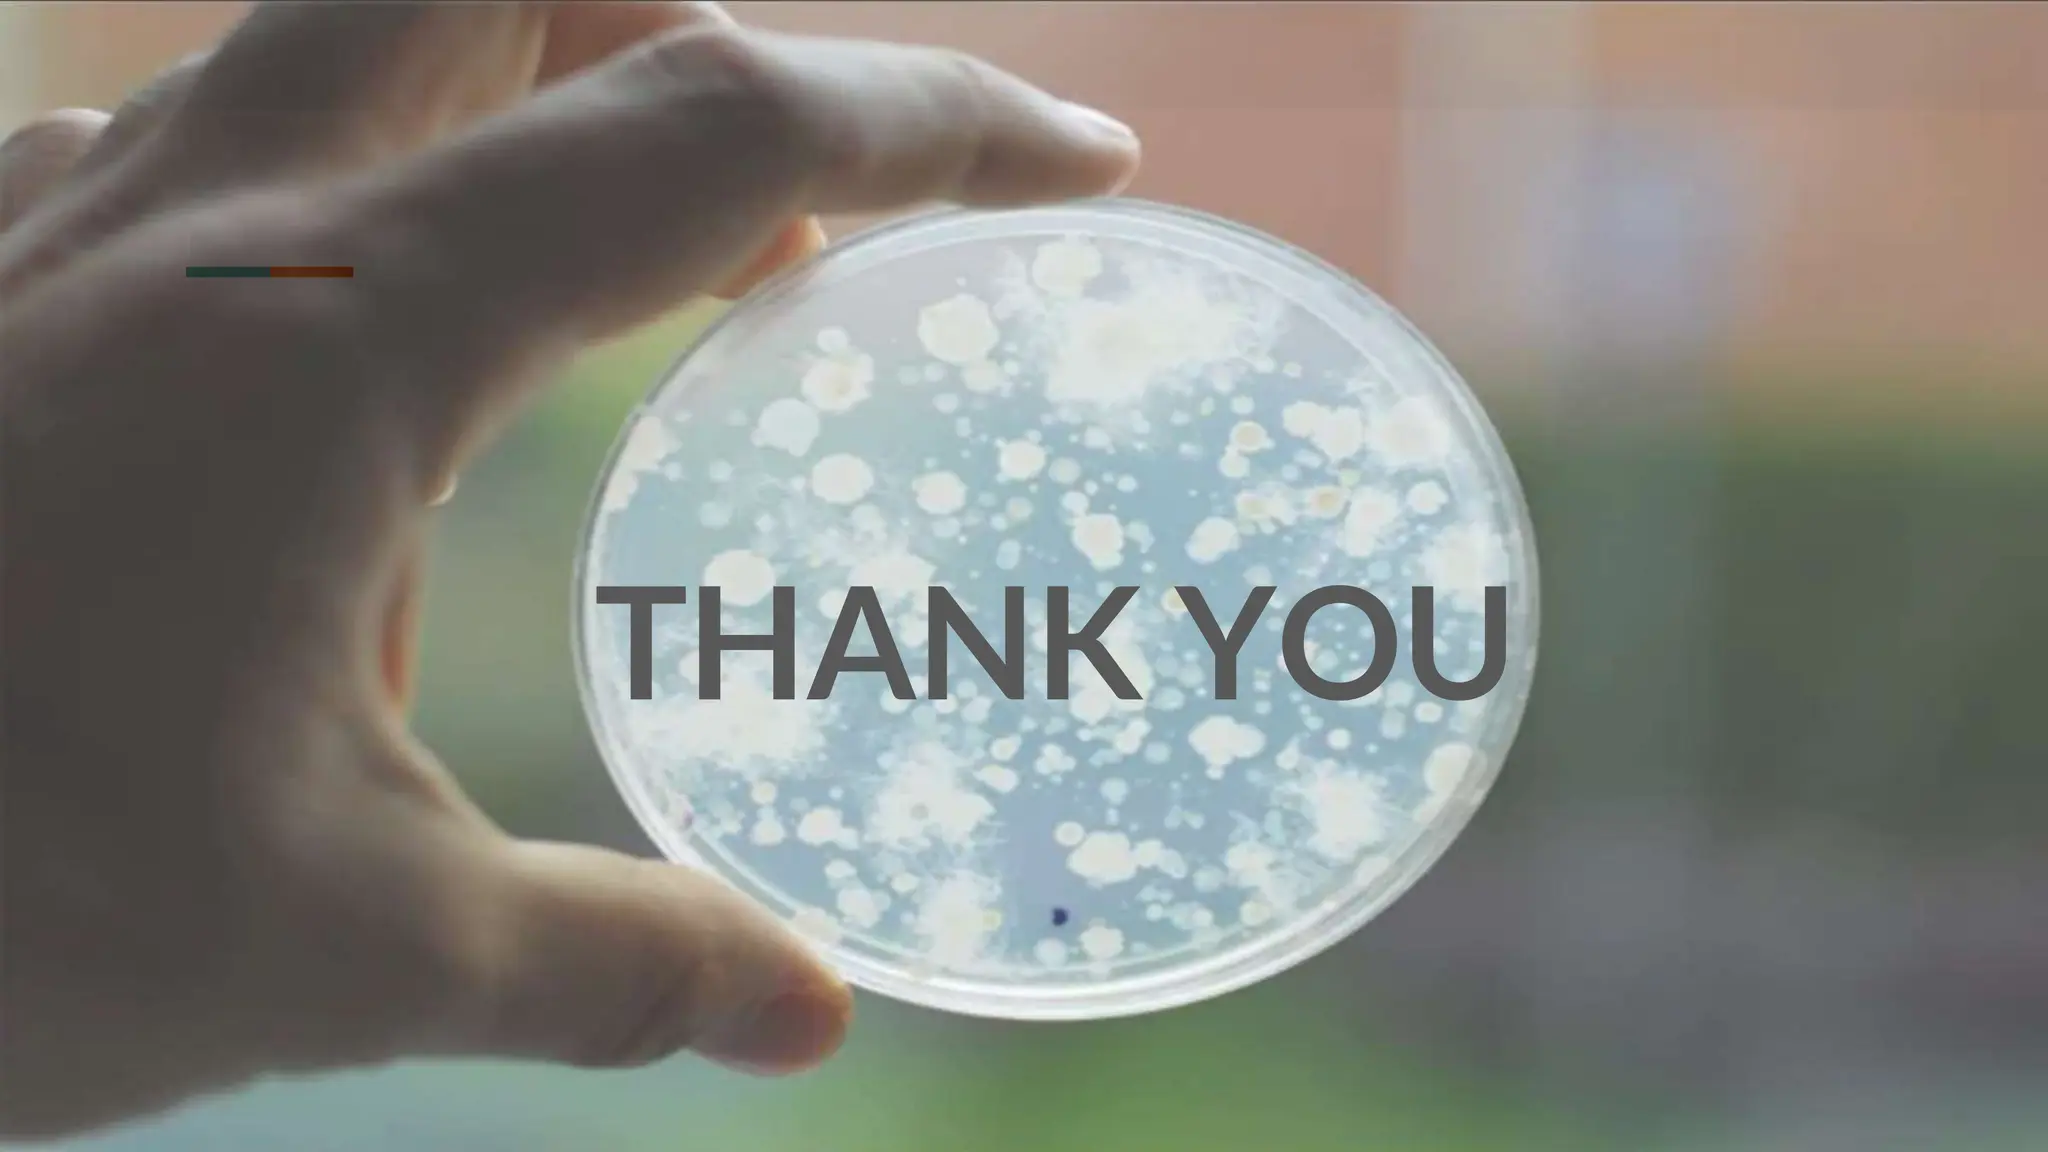
OPERATION THEATRE STERILITY TESTING.pptx

Explore the educational aspects of ppt - sterility test powerpoint presentation, free download - id:1994580 through countless informative visual resources. providing valuable teaching resources for educators and students alike. bridging theoretical knowledge with practical visual examples. Each ppt - sterility test powerpoint presentation, free download - id:1994580 image is carefully selected for superior visual impact and professional quality. Excellent for educational materials, academic research, teaching resources, and learning activities All ppt - sterility test powerpoint presentation, free download - id:1994580 images are available in high resolution with professional-grade quality, optimized for both digital and print applications, and include comprehensive metadata for easy organization and usage. Our ppt - sterility test powerpoint presentation, free download - id:1994580 images support learning objectives across diverse educational environments. The ppt - sterility test powerpoint presentation, free download - id:1994580 archive serves professionals, educators, and creatives across diverse industries. Instant download capabilities enable immediate access to chosen ppt - sterility test powerpoint presentation, free download - id:1994580 images. Whether for commercial projects or personal use, our ppt - sterility test powerpoint presentation, free download - id:1994580 collection delivers consistent excellence. Diverse style options within the ppt - sterility test powerpoint presentation, free download - id:1994580 collection suit various aesthetic preferences.